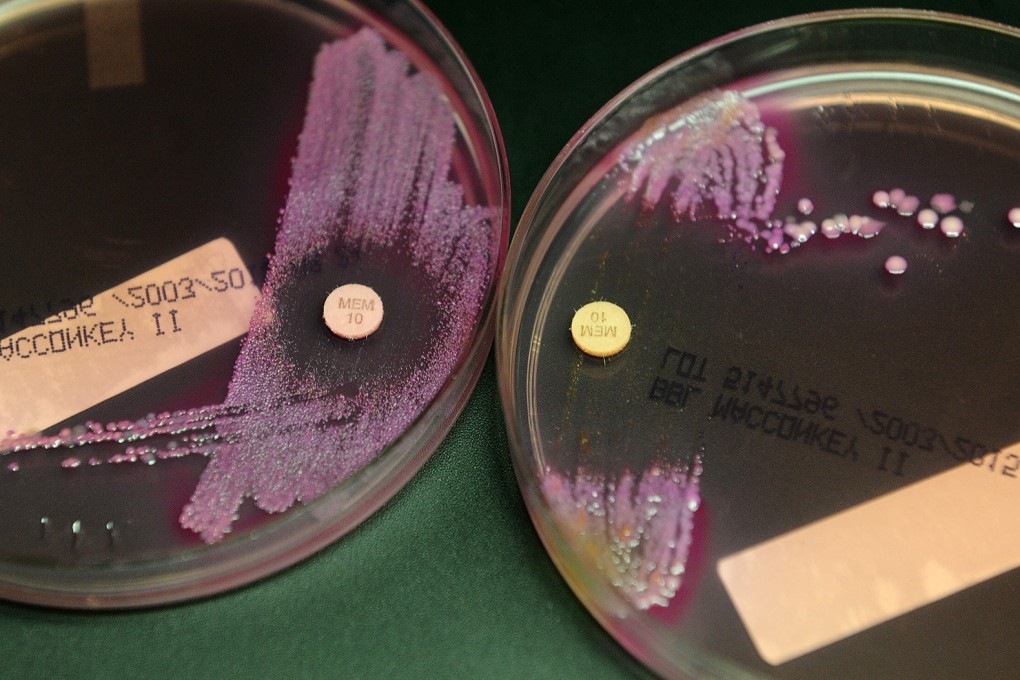
A bacterial sample at left contains carbapenem-resistant Enterobacteriaceae, able to grow despite the presence of an antibiotic. Photo: Los Angeles Times/TNS

Microbes 1, Humans 0: scientists spy on superbugs to see how they outsmart our antibiotics
- Team of researchers have been able to shed new light on how bacterial cells are becoming increasingly resistant to our drugs
Scientists have discovered yet another way that single-celled organisms have outsmarted us.
The tiny bacteria that live inside our guts have an ingenious way of withstanding the onslaught of antibiotics we throw at them, according to a report published on Thursday in the journal Science. The two-part system allows bacterial cells to stay alive until another bacterium can deliver a lifeline, packaged in a snippet of DNA.
Microbes 1, Humans 0.
“I’m afraid our findings are great news for bacterial cells – not so good for us,” said study leader Christian Lesterlin, a researcher in the Molecular Microbiology and Structural Biochemistry programme at Université Lyon in France.
Lesterlin and his colleagues already knew that superbugs could repel even our most modern medicines. What they did not know was how they managed to pull it off.
“These are amazing abilities they have, to be able to adapt and survive in harsh environments with antibiotics,” he said. “But the more we understand about it, the more we can do for human health.”